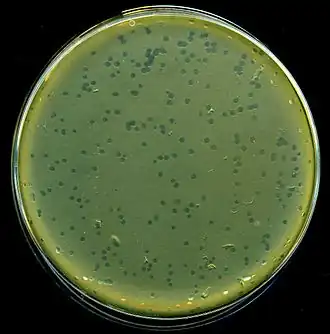

Фаг лямбда
| Фаг лямбда | ||||||
|---|---|---|---|---|---|---|
| ||||||
| Научная классификация | ||||||
|
Реалм: Царство: Тип: Uroviricota Класс: Caudoviricetes Порядок: Семейство: Siphoviridae Род: Lambdavirus Вид: Фаг лямбда |
||||||
| Международное научное название | ||||||
| Escherichia virus Lambda | ||||||
| Синонимы | ||||||
| Группа по Балтимору | ||||||
| I: дцДНК-вирусы | ||||||
| ||||||
Фаг λ, фаг лямбда (англ. Escherichia virus Lambda, ранее Enterobacteria phage lambda) — умеренный бактериофаг, который заражает кишечную палочку (Escherichia coli).
Цикл развития
Как только фаг попадает внутрь клетки хозяина, он может интегрировать себя в его ДНК. В этом состоянии λ называют профагом, он остается в геноме хозяина, внешне не проявляя своё присутствие. Профаг размножается с каждым делением клетки хозяина.
ДНК профага может экспрессироваться в тех случаях, когда наблюдаются признаки стресса в клетке-хозяине. Стресс может быть вызван голоданием, ядами (например антибиотиком), или другим факторами, которые могут повредить или уничтожить хозяина. В этом случае профаг активируется, выделяет себя из ДНК клетки-хозяина и вводит её в литический цикл. Активированный фаг уничтожает ДНК хозяина и производит большое количество собственной мРНК, чтобы произвести множество единиц фага. Когда все ресурсы хозяина исчерпаны от построения новых фагов, клетка-хозяин разрушается, клеточная мембрана разрывается, и новые фаги выходят во внешнюю среду[3].
Интеграция в геном

Интеграция фага λ происходит на специальном сайте в бактериальном геноме, названном attλ. Последовательность att сайта называют attB (состоит из компонентов B-O-B'), тогда как комплементарную последовательность в кольцевом геноме фага называют attP (состоит из компонентов P-O-P'). Сама интеграция — последовательный обмен (см. генетическая рекомбинация) происходит через образование структуры Холлидея и требует фагового белка Int и бактериального белка IHF (англ. integration host factor). И Int и IHF связываются с attP и формируют интрасому: ДНК-белковый комплекс, предназначенный для сайт-специфической рекомбинации ДНК фага и хозяина. Оригинальная BOB' последовательность заменяется интеграцией на B-O-P'-фаг ДНК-P-O-B'. ДНК фага теперь — часть генома хозяина.
История изучения
Фаг лямбда был обнаружен Эстер Ледерберг в 1950 году[4]. В 2016 году, вместе с другими бактериофагами, был переименован в Escherichia virus Lambda[5].
Примечания
- ↑ Таксономия вирусов (англ.) на сайте Международного комитета по таксономии вирусов (ICTV).
- ↑ ICTV Taxonomy History for Escherichia virus Lambda Архивная копия от 15 мая 2021 на Wayback Machine на сайте ICTV (англ.) (Дата обращения: 30 апреля 2019).
- ↑ М. Пташне. Переключение генов: Регуляция генной активности и фаг ламбда. — Москва: Мир, 1988. — 157 с. — ISBN 5030008543.
- ↑ Lederberg, E. M. Lysogenicity in Escherichia coli strain K-12 // Microbial Genetics Bulletin. — 1950. — Т. 1. — С. 5—9.
- ↑ To rename all (522) existing bacterial virus and 2 archaeal virus species : [англ.] : [арх. 30 апреля 2019] // ICTV. — Code assigned: 2015.025aB. — 2015. — 18 p.